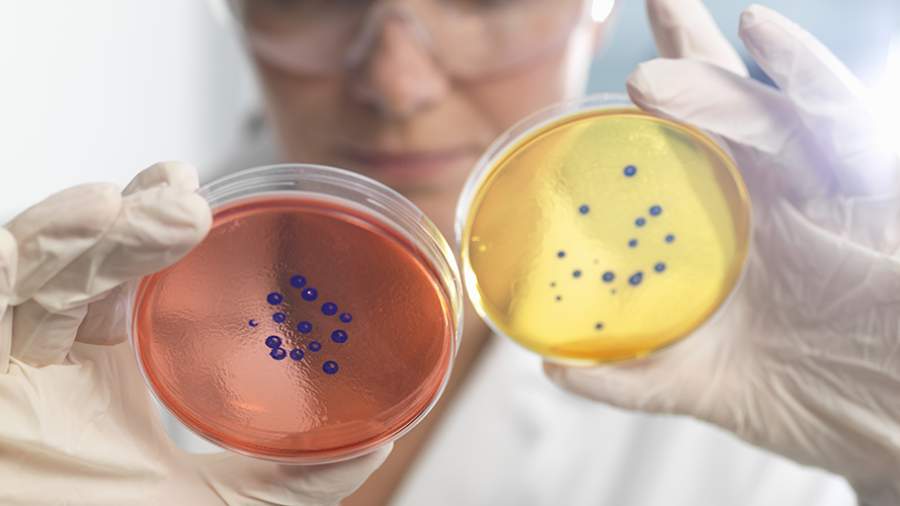

В США сообщили о скачке заражения смертельно опасной бактерией во Флориде
В США в штате Флорида зафиксировали всплеск случаев заражения смертельно опасной бактерией Vibrio vulnificus после затоплений в некоторых частях штата из-за прошедших ураганов «Хелен» и «Милтон». Об этом в среду, 23 октября, сообщила газета USA Today.
По данным министерства здравоохранения Флориды, выявлено 74 случая заражения этой бактерией, 13 из которых оказались со смертельным исходом.
«Вибриобактерии, обычно встречающиеся в теплых прибрежных водах, могут стать причиной заболевания человека при проглатывании или попадании загрязненной воды на открытые раны», — добавили в ведомстве, уточнив, что бактерии могут привести к быстрому разрушению кожи и мягких тканей вокруг раны.
Среди симптомов заболевания выделяют диарею, которая сопровождается спазмами желудка, тошнотой, рвотой и лихорадкой, а также озноб, низкое кровяное давление и волдыри на коже. В качестве лечения врачи применяют антибиотики, но в некоторых случаях может потребоваться ампутация конечностей, чтобы остановить быстрое разрушение плоти и чтобы инфекция не привела к летальному исходу.
«Представители здравоохранения советуют людям, испытывающим эти симптомы, немедленно обратиться за медицинской помощью после контакта с паводковыми водами», — указано в материале.
Ранее, 27 сентября, на юго-восточную часть США обрушился ураган «Хелен». В результате погибли более 220 человек, многие пропали без вести. На пике стихийного бедствия более 1 млн домохозяйств в штате остались без электричества.
За «Хелен» последовал ураган «Милтон», который вечером 9 октября достиг побережья штата Флорида. Из-за его продвижения по суше 1,5 млн человек остались без электричества. По данным телеканала ABC News, во время стихии погибли по меньшей мере 16 человек. 10 октября «Милтон» осушил залив Тампа и выгнал из привычной среды обитания крокодилов, которые начали появляться на улицах и участках частных домов. Президент США Джо Байден оценил ущерб от второго урагана в $50 млрд.




